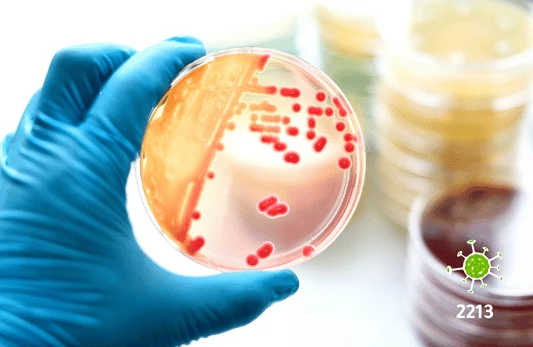
مسحة النيسرية البنية

تفاصيل التحليل
فحص مسحة بكتيريا السيلان (Neisseria gonorrhoeae)
احصل على نتائج فورية للكشف عن عدوى السيلان. يساعد هذا الفحص المجهري السريع في تحديد وجود البكتيريا المسببة للمرض، مما يضمن لك بدء العلاج فوراً وتجنب أي مضاعفات مستقبلية.
الصورة التوضيحية المرتبطة بهذا التحليل